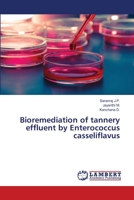
Bioremediation of tannery effluent by Enterococcus casseliflavus 3659493058 Book Cover

Microbial Composting Of Sugar Mill Wastes
Out of Stock

Recycling Of Sugar Mill Effluent For Spirulina Platensis Cultivation
Out of Stock

Supplementations In Spirulina Platensis Cultivation
$42.85

Vermicomposting of Market Wastes
Out of Stock
Bioremediation of tannery effluent by Enterococcus casseliflavus
Out of Stock